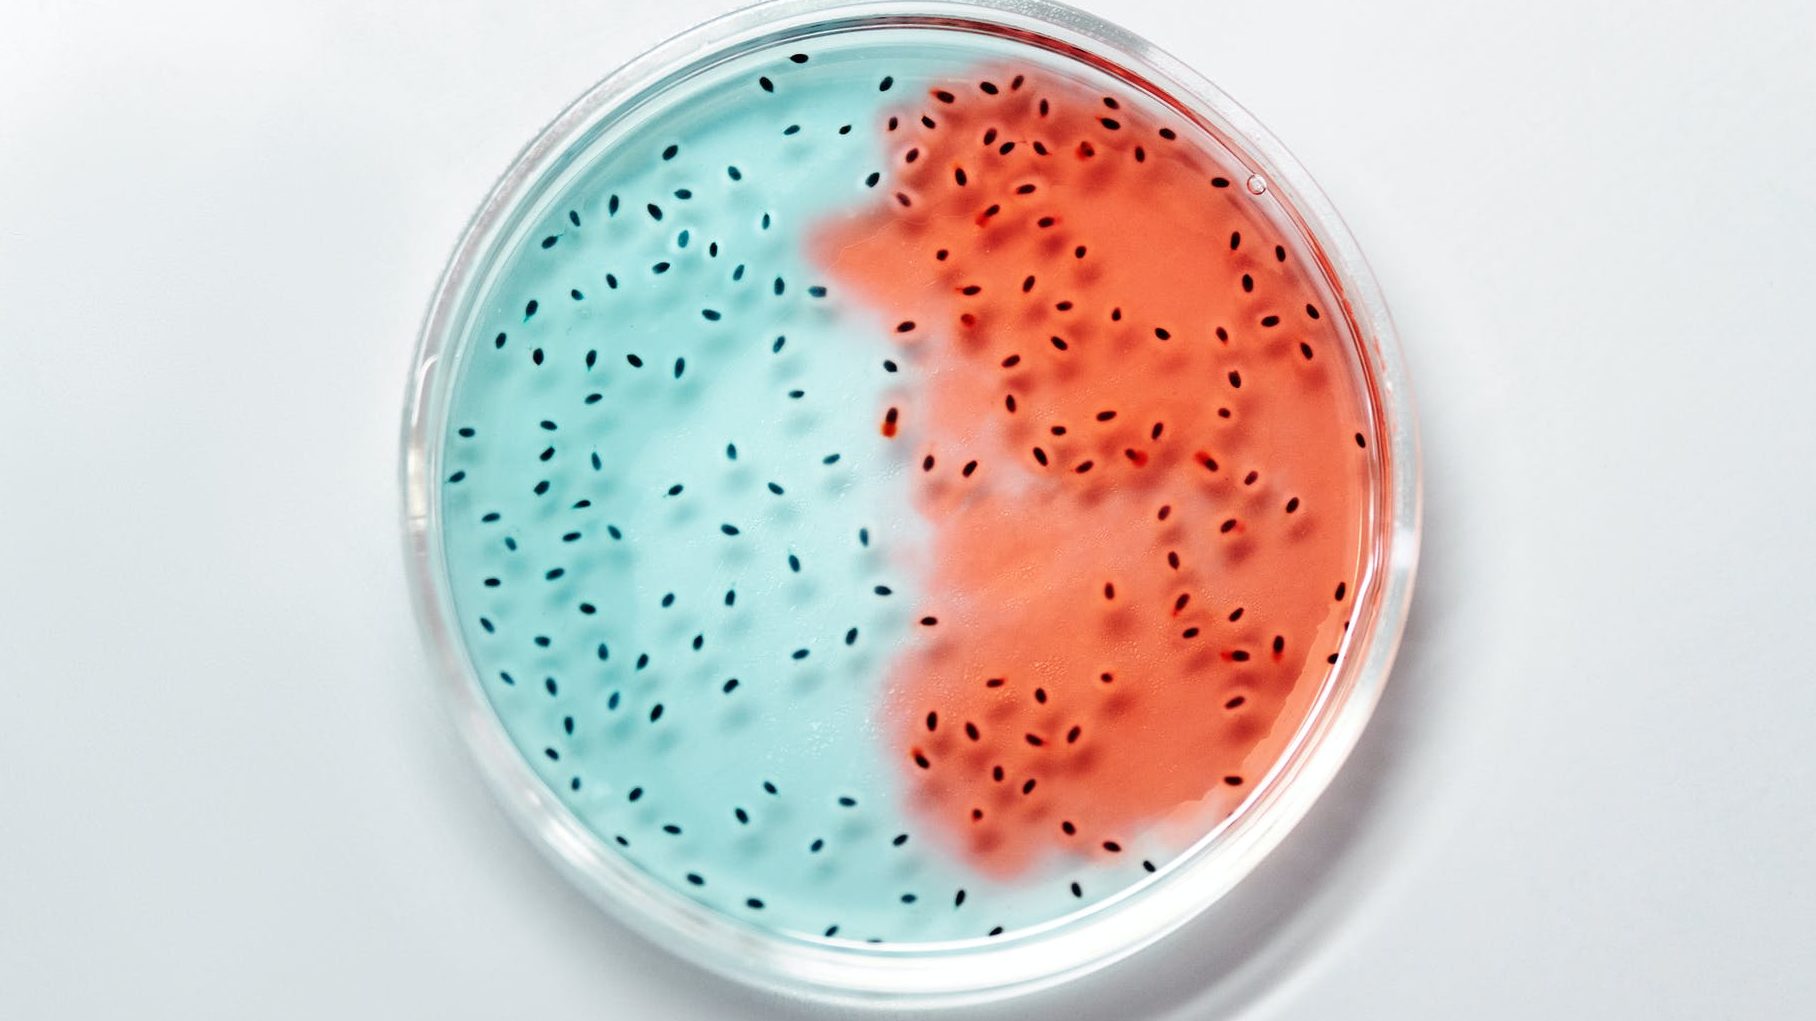

What Is It?
BASIC NUTRITION IS GIVING A PERSON THE CALORIES ,IN CARBOHYDRATES, PROTEINS AND FATS( MICRO-NUTRIENTS) THE VITAMINS AND MINERALS (MICRO-NUTRIENTS) TO KEEP YOU HEALTHY AND MAINTAIN YOUR WEIGHT.

Customized nutrition (now called Precision Nutrition) may sound like a new fad diet, but it is actually a credible, emerging area of research supported by the National Institutes of Health under the umbrella of precision medicine. Precision medicine seeks to improve the personalized treatment of diseases, and it is specific to dietary intake.
Precision nutrition develops interventions to prevent or treat chronic diseases based on a person’s unique characteristics including DNA, race, gender, health history, and lifestyle habits. It provides a safer and more effective way to prevent and treat disease by providing more accurate and targeted strategies.
This field assumes that each person may have a different response to specific foods and nutrients, so that the best diet for one individual may look very different than the best diet for someone else. The concept of precision nutrition or individual blueprint requires a unique dietary plan to be successful.
For example if you take antibiotics frequently we have to focus on changing the microbiome in your gut by changes in the diet.

how does it work?
Precision nutrition (aka personalized nutrition), focuses on the individual rather than groups of people. Many research studies on nutrition and types of diets provide useful information for communities and the general population.
High-quality nutrition studies have shown that for the average person, eating more vegetables, whole grains, and lean proteins while eating less highly processed foods made with added sugars and salt can help reduce the risk of various diseases.
There are substantial variations in blood responses of glucose and triglycerides even if individuals are eating identical meals.
address EXISTING RISK FACTORS and DISEASES.
People with different diseases have risk factors for diseases can be made worse or better based on the diet.
- For example if a woman has rheumatoid arthritis this may indicate the possibility developing this or similar conditions and the diet focus heavily on anti-inflammatory diets.
- If the person has stress or anxiety, the diet should focus on diets which has less stimulated components.
- If there is a family history of cancer, it is very important to avoid foods and additives which may increase the risk.
- For sleep disorders or shift workers, diet should also be adjusted based on their day night rhythm.
- Insulin Resistance is related to Obesity, Prediabetes, Diabetes, Irregular Periods, Infertility and Facial Hair Related to Polycystic Ovarian Disease.
- Diet for persons with high high Cholesterol and high Triglycerides
- Diets for persons with slow metabolism
- Diets for menopause
The types and amount of bacteria we have is unique to each individual. Precision nutrition also considers microbiome. Trillions of bacteria (primarily in our gut) play a key role in various daily internal operations. Our diets can determine which types of bacteria live in our digestive tracts, and the types of bacteria we have in our gut determines how we break down certain foods and what types of foods are most beneficial for our bodies. Thus prebiotics, probiotics and postbiotics in the food and supplement affect your health and happiness, and much more than we ever dreamed of ten years ago!
You deserve to have the diet that you can enjoy and believe in. Without this aspect, you might struggle to follow it and understand the overall strategy.
Applying Precision Nutrition iN the future – The DNA profile
How one’s DNA may be related to the intake and metabolism of certain nutrients can predict how a person responds to a specific diet.
The measurement of metabolites (small molecules created during the breakdown and digestion of food) reveals a person’s long-term dietary patterns, whether it be eating fruits and vegetables regularly, or having a high intake of saturated fat from a daily intake of meats and butter.
Precision nutrition would see if there is an association between a person’s metabolic “signature” created by these dietary patterns and their risk of developing T2DM.
The metabolic testing used with precision nutrition might help to determine how a person’s body would respond to a specific diet.
Discovering types of gut bacteria helps improve blood glucose control. It also helps implement dietary patterns that change one’s microbiome, to ultimately support the growth and maintenance of these specific gut bacteria.
Precision nutrition in the future will study a person’s DNA and how they’ll respond to a food. One example is the same amount of food will cause one person to gain weight and the other to lose weight. Another great example is coffee. Ever notice how some people are unaffected after drinking cup after cup of coffee, while you may feel jittery and high-strung after only one cup? Coffee beans contain plant chemicals with health benefits, but not everyone can tolerate the side effects of the caffeine content.
Genes may determine how fast or slowly caffeine is metabolized. They are also associated with anti-inflammatory effects and a lower risk of certain chronic diseases. Precision nutrition may use genetic information like this to determine whether an individual would benefit from drinking more or less coffee.
As life conditions change, and the knowledge base of medical, new blood tests and genetic studies become available, your diet will have to change with time.
Explore and experience the benefits of personalized nutrition guidance, beyond general health recommendations and weigh loss programs based on a person’s weight. A person can be obese by the standard definition of weight and a thin person can be unhealthy, though both are totally asymptomatic!